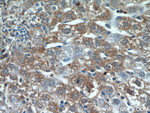
HSD17B4 Antibody in Immunohistochemistry (Paraffin) (IHC (P))

Search
Proteintech
HSD17B4 Polyclonal Antibody
{{$productOrderCtrl.translations['antibody.pdp.commerceCard.promotion.promotions']}}
{{$productOrderCtrl.translations['antibody.pdp.commerceCard.promotion.viewpromo']}}
{{$productOrderCtrl.translations['antibody.pdp.commerceCard.promotion.promocode']}}: {{promo.promoCode}} {{promo.promoTitle}} {{promo.promoDescription}}. {{$productOrderCtrl.translations['antibody.pdp.commerceCard.promotion.learnmore']}}

Please note: We are reviewing Western blot images included in the antibody testing data in our catalog, including those provided by third parties. Unless expressly labeled or annotated as “raw-unedited”, Western blot images included in the antibody testing data in our catalog may have been edited, optimized or otherwise adjusted for presentation.
产品信息
15116-1-AP
种属反应
已发表种属
宿主/亚型
分类
类型
抗原
偶联物
形式
浓度
规格
纯化类型
保存液
内含物
保存条件
运输条件
产品详细信息
Immunogen sequence: GSGVVIIMD VYSYSEKELI CHNQFSLFLV GSGGFGGKRT SDKVKVAVAI PNRPPDAVLT DTTSLNQAAL YRLSGDWNPL HIDPNFASLA GFDKPILHGL CTFGFSARRV LQQFADNDVS RFKAIKARFA KPVYPGQTLQ TEMWKEGNRI HFQTKVQETG DIVISNAYVD LAPTSGTSAK TPSEGGKLQS TFVFEEIGRR LKDIGPEVVK KVNAVFEWHI TKGGNIGAKW TIDLKSGSGK VYQGPAKGAA DTTIILSDED FMEVVLGKLD PQKAFFSGRL KARGNIMLSQ KLQMILKDYA KL (436-736 aa encoded by BC003098)
靶标信息
Peroxisomal multifunctional enzyme type 2 is a protein that in humans is encoded by the HSD17B4 gene. The protein encoded by this gene is a bifunctional enzyme that is involved in the peroxisomal beta-oxidation pathway for fatty acids. It also acts as a catalyst for the formation of 3-ketoacyl-CoA intermediates from both straight-chain and 2-methyl-branched-chain fatty acids. Defects in this gene that affect the peroxisomal fatty acid beta-oxidation activity are a cause of D-bifunctional protein deficiency (DBPD). An apparent pseudogene of this gene is present on chromosome 8. Multiple alternatively spliced transcript variants encoding distinct isoforms have been found for this gene.
仅用于科研。不用于诊断过程。未经明确授权不得转售。
生物信息学
蛋白别名: 17-beta-HSD 4; 17-beta-HSD IV; 17-beta-hydroxysteroid dehydrogenase 4; 17beta-estradiol dehydrogenase type IV; 3-alpha,7-alpha,12-alpha-trihydroxy-5-beta-cholest-24-enoyl-CoA hydratase; beta-hydroxyacyl dehydrogenase; beta-keto-reductase; D-3-hydroxyacyl-CoA dehydratase; D-bifunctional protein; D-bifunctional protein, peroxisomal; DBP; epididymis secretory sperm binding protein; hydroxysteroid (17-beta) dehydrogenase 4 isoform HSD17B4_1; hydroxysteroid (17-beta) dehydrogenase 4 isoform HSD17B4_2; hydroxysteroid (17-beta) dehydrogenase 4 isoform HSD17B4_3; hydroxysteroid (17-beta) dehydrogenase 4 isoform HSD17B4_4; hydroxysteroid dehydrogenase 4; MFE-2; MFP-2; Multifunctional protein 2; Peroxisomal multifunctional enzyme type 2; peroxisomal multifunctional enzyme type II; peroxisomal multifunctional protein 2; Short chain dehydrogenase/reductase family 8C member 1; unnamed protein product
基因别名: 17-beta-HSD; 17[b]-HSD; DBP; 4; EDH17B4; HSD17B4; MFE-2; MFP-2; MFP2; MPF-2; perMFE-2; PRLTS1; SDR8C1
UniProt ID: (Mouse) P51660, (Rat) P97852
Entrez Gene ID: (Human) 3295, (Mouse) 15488, (Rat) 79244




